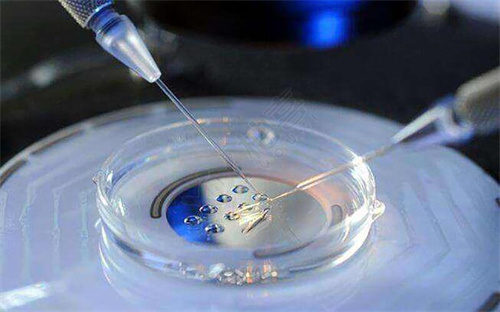

试管取卵必须要打夜针吗?盘点试管婴儿取卵打夜针的作用
更新时间:2025-01-15 02:57:14 来源:?kuadu-yy 责任编辑:?kuadu-yy
正常情况下,不孕不育症夫妇做试管婴儿取卵之前一般是必须打夜针的,该针剂主要用于促进卵泡成熟和最终的排卵,以便进行取卵。这种药物通常是人类绒毛膜促性腺激素,注射时间通常在取卵前的34-38小时,通常安排在晚上进行,因此得名“夜针”。主要目的是确保卵子的质量和数量,以及使得取卵过程更为可控和高效。但具体什么时候注射,建议各位不孕不育症夫妇以医务工作人员的嘱咐和建议为准。

试管取卵必须要打夜针吗
在“试管婴儿”治疗过程中,卵泡发育到一定阶段时,医生会根据激素水平、B超卵泡监测和患者自身情况,决定注射一定量的人绒毛膜促性激素(HCG)或者短效促性腺激素释放激素激动剂(GnRH-a),以此促进卵母细胞的成熟。
这是“试管婴儿”促排卵过程中,最后也是最关键的一步,而由于这个针一般都安排在晚上打,所以又被称为“打夜针”。该针剂一般都在晚上注射,是因为注射“夜针”后35-37小时左右卵子成熟,为了能合理地安排取卵手术、男方取精、卵子授精、胚胎培养等工作。为了更加翻边做试管婴儿取卵,一般是需要打夜针的,但打夜针的时间还需要以医院的安排为准。
盘点试管婴儿取卵打夜针的作用
打夜针在试管婴儿治疗中是一个非常关键的步骤,而针剂的的作用主要有四个,分布是促进卵子成熟、调节排卵时机、预防早期排卵、增加获卵率等等:
1、促进卵子成熟:夜针的主要作用是促进卵泡中的卵子成熟,使得卵子从卵泡壁脱落,更容易被收集;
2、调节排卵时机:夜针的使用可以帮助医生更好地控制排卵的时机,与取卵手术的时间相匹配,确保取出的卵子是成熟的;
3、预防早期排卵:夜针可以预防在取卵前卵泡过早释放卵子,确保卵子的质量和数量;
4、提高受孕机会:通过促进多个卵子的生长和成熟,夜针增加了受精卵的数量,从而提高了移植后胚胎的着床率和妊娠率;
5、增加获卵率:恰当的夜针使用可以促使更多的卵泡同步成熟,从而提高获卵率,尤其对于卵巢功能较差的患者来说,打夜针可以最大程度地发挥现有卵泡的潜力。
夜针是试管婴儿治疗中一步重要的环节,可以促进受精卵发育,提高受精卵存活率,从而最大程度地提高夫妻的生育愿望。虽然夜针的作用和分类不尽相同,但一定要根据个人情况进行定制,以保证最佳的治疗效果。